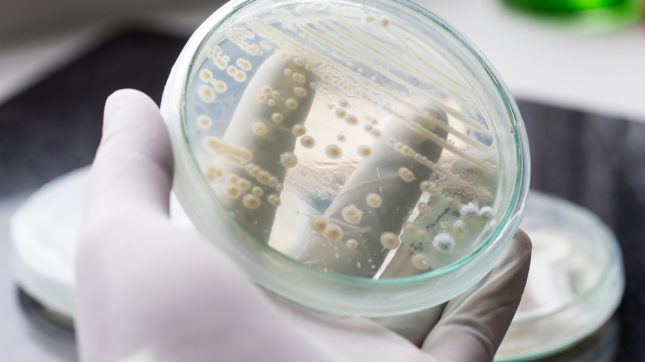
שמרים. אילוסטרציה

החיידקים החיים בתוך המעיים ממלאים תפקיד במצבים בריאותיים רבים, כולל מחלות מעי דלקתיות כמו קרוהן וקוליטיס. חוקרים פיתחו פרוביוטיקה מותאמת אישית לטיפול במחלה, כולל הפחתת הדלקת, שיקום רקמות שנפגעו, והשבת אוכלוסיית החיידקים המקורית במודל של עכבר. את הפרוביוטיקה הכינו משמרים המשמשים לייצור בירה, באמצעות טכנולוגיית עריכת גנים CRISPR. המחקר הפרה-קליני פורסם בכתב העת Nature Medicine, והחוקרים מתכננים לערוך מחקרי בטיחות נוספים לפני בדיקת הפרוביוטיקה בבני אדם.
במעיים של בני אדם חיים סוגים רבים של חיידקים, פטריות ושמרים השומרים על איזון עדין, עם השפעה מרחיקת לכת על בריאותנו. מחקרים הראו כי מצבים כרוניים מסוימים כמו מחלות מעי דלקתיות קשורים להפרה של איזון זה. צוות חוקרים מבוסטון יצרו תוסף שיכול לחוש בהפרת האיזון במיקרוביום ולהשיב את האיזון כדי לטפל במחלות כרוניות. השמרים המהונדסים גנטית הגיבו בהצלחה לדלקת והקלו על תסמיניה אצל עכברים.
התסמינים השכיחים של מחלות מעי דלקתיות כוללים שלשולים, כאבי בטן, צואה מדממת, עייפות וירידה בלתי מוסברת במשקל. מחקרים קודמים הראו שלאנשים עם מחלות מעי דלקתיות יש מיקרוביום מעיים לא מאוזן, המכיל מגוון נמוך יותר של חיידקים, ואחוז גבוה יותר של חיידקים שגורמים לדלקת. מדענים סבורים שפרוביוטיקה עשויה לסייע בהשבת איזון זה ובהפחתת דלקת. הבעיה היא שהפרוביוטיקה הקיימת בשוק עברה תהליכי אופטימיזציה במעיים של אנשים בריאים.
מטרת החוקרים היתה לייצר פרוביוטיקה שיכולה לעצור תהליכים דלקתיים, לתקן נזק לרקמות, ולאזן מחדש את אוכלוסיית החיידקים במעיים, והתברר ששמרים יכולים לבצע את כל הפעולות האלה. השמרים בהם השתמשו נקראים Saccharomyces cerevisiae והם משמשים גם בהכנת בירה, יין, ואפייה. שמרים אלה חיים באופן טבעי במעיים האנושיים כחלק ממיקרוביום בריא. החוקרים השתמשו בטכנולוגיית עריכת גנים (CRISPR-Cas9) כדי להכניס לשמרים גן שמופעל על ידי דלקת במעי. כאשר השמרים חשים בדלקת, הם מפרישים אנזים שמפרק מולקולות דלקתיות הנקראות אדנוזין טרי-פוספט חוץ תאי (eATP) שמפחית את עוצמת הדלקת.
השמרים המהונדסים מייצרים כמויות שונות של האנזים, כתלות בכמות הסיגנלים הדלקתיים. כך השמרים מספקים מענה מקומי לאתרי דלקת ספציפיים במעיים. החוקרים בדקו את הפרוביוטיקה בעכברים עם סוגים שונים של מחלות מעי לאחר מתן השמרים המהונדסים דרך הפה. הם גילו כי העכברים מבטאים פחות גנים שמקדמים דלקת במעי הגס. הדבר גרם לדיכוי הדלקת במעיים ולהפחתת פיברוזיס – מצב בו רירית המעיים הופכת למצולקת ומעובה, מה שעלול לגרום לחסימת המעיים. במקרים מסוימים הפרוביוטיקה המהונדסת היתה יעילה כמו או יותר מתרופות לטיפול באנשים עם מחלות מעי דלקתיות, כמו נוגדנים חוסמי TNF.
לפני שניתן יהיה להשתמש בפרוביוטיקה המהונדסת בבני אדם, יהיה צורך לבצע מחקרי בטיחות נוספים ולעסוק בניסויים קליניים בקנה מידה גדול. בכוונת החוקרים גם לתכנון שמרים שיהיו מסוגלים לזרז שיקום של רקמות שנפגעו על ידי הדלקת. החוקרים מקווים גם ליישם את השיטה בדלקות ברקמות אחרות בגוף. קבוצת המחקר בחנה בעבר את תפקיד הדלקת במוח בטרשת נפוצה והתכנון הוא לבדוק אם שמרים מהונדסים גנטית אלה יכולים לטפל גם בדלקת הזאת.